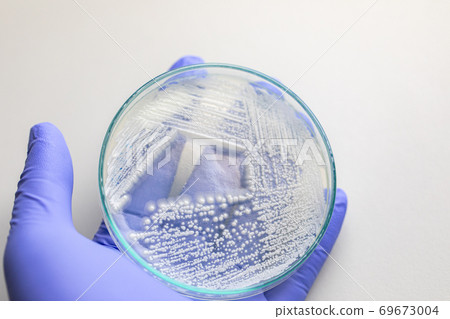
Yeast in petri dish, Microbiology for education in laboratories. 69673004

Subscription
Stock Photo: Yeast in petri dish, Microbiology for education in laboratories.
Item number : 69673004 See all
This Stock Photo, whose title is "Yeast in petri dish, Microbiology for education..."[69673004], includes tags of microscope, test, lab. The author of this item is Sinhyu (No.1781464). Sizes from S to XL are available and the price starts from US$5.00. You can download watermarked sample data (comp images), check the quality of images, and use Lightbox after signing up for free. See all
Yeast in petri dish, Microbiology for education in laboratories.
Scale
* You can move the image by dragging it.
Credits(copyright) : Sinhyu / PIXTA
- About Model and Property Release
- Made at : 2020-09-11
- Views : 94
- Past purchases : No
- Contact Contributor to Ask About This Item